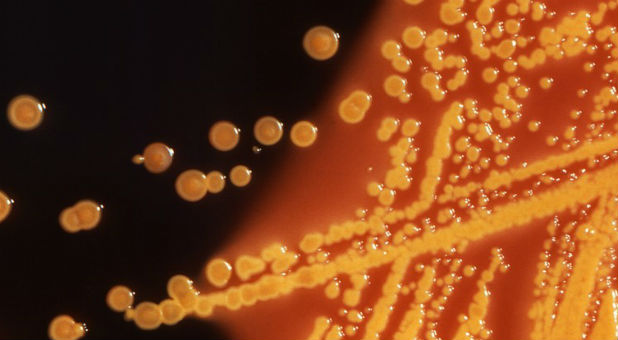
Colonies of E. coli bacteria grown on a Hektoen enteric (HE) agar plate are seen in a microscopic image.

After two confirmed U.S. cases of a superbug that thwarts a last-resort antibiotic, infectious disease experts say they expect more cases in coming months because the bacterial gene behind it is likely far more widespread than previously believed.
Army scientists in May reported finding E. coli bacteria that harbor a gene which renders the antibiotic colistin useless. The gene, called mcr-1, was found in a urine sample of a Pennsylvania woman being treated for a urinary tract infection.
On Monday, researchers confirmed preliminary findings that E. coli carrying the same mcr-1 gene were found in a stored bacterial sample of a New York patient who had been treated for an infection last year, as well as in patient samples from nine other countries.
The report came from a global effort called the SENTRY Antimicrobial Surveillance Program, led by Mariana Castanheira of JMI Laboratories based in North Liberty, Iowa.
The mcr-1 superbug has been identified over the past six months in farm animals and people in about 20 countries, including China, Germany and Italy.
The bacteria can be transmitted by fecal contact and poor hygiene, which suggests a far wider likely presence than the documented cases so far, according to leading infectious disease experts.
Health officials fear the mcr-1 gene, carried by a highly mobile piece of DNA called a plasmid, will soon be found in bacteria already resistant to all or virtually all other types of antibiotics, potentially making infections untreatable.
“You can be sure (mcr-1) is already in the guts of people throughout the United States and will continue to spread,” said Dr. Brad Spellberg, professor of medicine at the University of Southern California.
Dr. David Van Duin, an infectious disease expert at the University of North Carolina in Chapel Hill, said he expects more documented U.S. cases of mcr-1 in coming months because it is already here and will spread from abroad. “We will see a lot more of this gene.”
Colistin causes kidney damage, but doctors have opted for it as other antibiotics increasingly fail. Its overuse, especially in overseas farm animals, has allowed bacteria to develop resistance to it.
PAST AND PRESENT INFECTIONS
To track the mcr-1 gene, U.S. hospitals are working together with state and federal agencies to test bacteria samples of patients that have recently been treated for infections. Many of the largest research hospitals are examining samples of antibiotic-resistant bacteria that have long been stored in their freezers.
Gautam Dantas, associate professor of pathology at Washington University Medical Center in St. Louis, has tested hundreds of U.S. samples of archived bacteria in recent months and has not yet detected mcr-1. But he expects dozens of confirmed cases of the gene will be documented by next year in the country, mostly among current patients.
The concern of many disease experts is that mcr-1 could soon show up in bacteria also resistant to carbapenems, one of the few remaining dependable classes of antibiotics. In that event, with colistin no longer a last-ditch option, some patients would have to rely on their immune systems to fight off infection.
“Within the next two to three years, it’s going to be fairly routine for infections to occur in the United States for which we have no (effective) drugs available,” Dantas said.
Castanheira also believes mcr-1 will find its way into carbapenem-resistant bacteria, formally known as carbapenem-resistant enterobacteriaceae (CRE).
In an interview, she said the resulting virtually impervious bacterium would likely spread slowly inside the United States because CRE themselves are not yet widespread in the country, giving drugmakers some time to create new antibiotics.
Beginning in August, the U.S. Centers for Disease Control and Prevention will use $21 million to expand surveillance at laboratories operated by all 50 state health departments and seven larger regional labs. The federal funding will help pay for more-sensitive equipment to test for antibiotic resistance in bacteria samples provided by hospitals.
Jean Patel, deputy director of the CDC’s Office of Antimicrobial Resistance, said the effort will provide the CDC improved national surveillance of antibiotic-resistance trends, including any spread of mcr-1.
“This is data for action,” she said, adding that special procedures to prevent infections from spreading in hospitals could be taken once a patient is identified with mcr-1 related infections or with multidrug-resistant bacteria. {eoa}
© 2016 Thomson Reuters. All rights reserved.